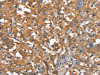

Cusabio Polyclonal Antibodies
CAPZA1 Antibody | CSB-PA173074
- SKU:
- CSB-PA173074
- Availability:
- 3 to 7 Working Days
Description
CAPZA1 Antibody | CSB-PA173074 | Cusabio
CAPZA1 Antibody is Available at Gentaur Genprice with the fastest delivery.
Online Order Payment is possible or send quotation to info@gentaur.com.
Product Type: Polyclonal Antibody
Target Names: CAPZA1
Aliases: capping protein (actin filament) muscle Z-line, alpha 1
Background: CAPZA1 is a member of the F-actin capping protein alpha subunit family. This gene encodes the alpha subunit of the barbed-end actin binding protein. The protein regulates growth of the actin filament by capping the barbed end of growing actin filaments. F-actin-capping proteins bind in a Ca2+-independent manner to the fast growing ends of actin filaments (barbed end) thereby blocking the exchange of subunits at these ends. Unlike other capping proteins (such as gelsolin and severin), these proteins do not sever actin filaments.
Isotype: IgG
Conjugate: Non-conjugated
Clonality: Polyclonal
Uniport ID: P52907
Host Species: Rabbit
Species Reactivity: Human, Mouse, Rat
Immunogen: Synthetic peptide of human CAPZA1
Immunogen Species: Human
Applications: ELISA, IHC
Tested Applications: ELISA, IHC;ELISA:1:1000-1:2000, IHC:1:25-1:100
Purification Method: Antigen affinity purification
Dilution Ratio1: ELISA:1:1000-1:2000
Dilution Ratio2: IHC:1:25-1:100
Dilution Ratio3:
Dilution Ratio4:
Dilution Ratio5:
Dilution Ratio6:
Buffer: -20°C, pH7.4 PBS, 0.05% NaN3, 40% Glycerol
Form: Liquid
Storage: Upon receipt, store at -20°C or -80°C. Avoid repeated freeze.
Initial Research Areas: Signal Transduction
Research Areas: Signal transduction